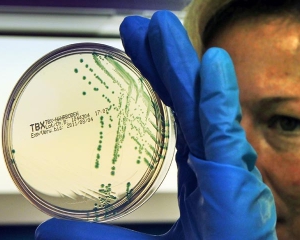

В среду 8 июня в университетской больнице в Кошице (восточная Словакия) медики подтвердили наличие бактерий E.coli у 25-летнего мужчины. Это первый такой случай, пишет словацкая пресса.
Как сообщается, он был перевезен из больницы города Прешов в тяжелом состоянии, где ему был поставлен диагноз гемолитический уремический синдром. У больного отказывают почки, идет кровавый понос.
По данным СМИ, в Словакии в последние дни значительно снизились продажи овощей из страха населения перед инфекцией, власти со своей стороны также начали тщательнее проверять импортируемую сельскохозяйственную продукцию. Некоторые поставщики значительно снизили цены на овощи.
Как сообщалось, в Германии число умерших от заражения кишечной палочкой E.coli в четверг возросло до 29 человек. Еще один человек скончался в Швеции. Число заразившихся кишечной палочкой E.coli почти 3 тыс. человек
До сих пор не ясен источник заражения болезнетворным штаммом E.coli
Комментарии